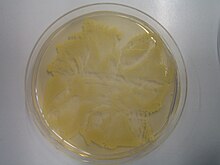

Staphylococcus aureus
Staphylococcus aureus | ||||||||||||
---|---|---|---|---|---|---|---|---|---|---|---|---|
![]() Staphylococcus aureus | ||||||||||||
Systematik | ||||||||||||
| ||||||||||||
Wissenschaftlicher Name | ||||||||||||
Staphylococcus aureus | ||||||||||||
Rosenbach, 1884 |
Staphylococcus aureus ist ein kugelförmiges, grampositives Bakterium, das häufig in Haufen (Traubenform) angeordnet ist (Haufenkokken). Staphylokokken bewegen sich nicht aktiv und bilden keine Sporen. Die Größe liegt üblicherweise zwischen 0,8 und 1,2 µm. Staphylococcus aureus ist weit verbreitet, kommt in vielen Habitaten vor, lebt meistens als harmloser, beim Menschen zur normalen Besiedlungsflora der Haut und Schleimhaut gehörender Saprobiont und Kommensale, kann aber auch pathogen sein und neben Haut- und Weichgewebsinfektionen auch Lungenentzündung, Hirnhautentzündung, Endokarditis und sogar ein toxisches Schocksyndrom und Sepsis verursachen. Bezüglich ihres Ansprechens auf Antibiotika wurden Staphylokokken in Methicillin-sensible (MSSA) und Methicillin-resistente (MRSA) Stämme eingeteilt.
Name
Die Bezeichnung Staphylococcus aureus besteht aus einem latinisierten Singular zweier altgriechischer Bestandteile, nämlich σταφυλή staphylé ‚Weintraube‘ und κόκκος kókkos ‚Kern‘, ‚Korn‘,[1] ‚Beere‘, sowie dem lateinischen aureus ‚golden‘. Die Farbbezeichnung rührt daher, dass die meisten Stämme von Staphylococcus aureus orangegelb („goldgelb“) gefärbt sind (seine Kolonien auf Agargelplatten sind so gefärbt) und dass Staphylococcus aureus lange Zeit als Verursacher des sogenannten „goldgelben“ Eiters galt.
Die orangegelbe Farbe wird durch den Farbstoff Staphyloxanthin in der Zellmembran des Bakteriums hervorgerufen, ein Carotinoid aus der Gruppe der Xanthophylle. Dieses Pigment wirkt als Antioxidationsmittel und unterbindet chemische Reaktionen mit Sauerstoff oder anderen Oxidationsmitteln. So schützt sich das Bakterium vor einigen Stoffen, die ein Immunsystem zur Abwehr nutzt.[2]
Vorkommen
Staphylococcus aureus kommt fast überall in der Natur vor, auch auf der Haut und der Schleimhaut von warmblütigen Tieren, bei 25 bis 30 % aller Menschen auf der Haut und in den oberen Atemwegen. Außerdem kommt Staphylococcus aureus in Nahrungsmitteln und in Gewässern vor.
Physiologische Eigenschaften
Staphylococcus aureus ist chemoorganotroph, respiratorisch und fermentativ, also fakultativ anaerob: Ist Sauerstoff vorhanden, werden organische Stoffe damit oxidiert und diese Oxidation als Energiequelle genutzt; ist dagegen kein Sauerstoff verfügbar, bildet das Bakterium in einem fermentativen Energiestoffwechsel Milchsäure aus Kohlenhydraten oder es kann bei Verfügbarkeit von Nitrat dieses statt Sauerstoff als Oxidans in einem respiratorischen Energiestoffwechsel verwenden. Staphylococcus aureus bildet Koagulase und wirkt hämolytisch.
Pathogenität
Meist löst Staphylococcus aureus bei Menschen und Tieren keine Krankheitssymptome aus. Man spricht in diesem Falle von einer klinisch asymptomatischen Besiedlung oder Kolonisation des Wirts mit dem potentiell pathogenen Bakterium („Kolonisationskeim“). Bekommt das Bakterium durch günstige Bedingungen oder ein schwaches Immunsystem des Wirts die Gelegenheit, sich auszubreiten, kommt es zu Krankheitserscheinungen. Beim Menschen kommt es zu Hautentzündungen (Furunkel, Karbunkel), Muskelerkrankungen (Pyomyositis), in ungünstigen Fällen auch zu lebensbedrohlichen Erkrankungen wie Lungenentzündung, Herzinnenhautentzündung (Endokarditis), Toxisches Schocksyndrom (TSS) und Blutvergiftung (Sepsis). Falls diese Bakterien Resistenzen gegen mehrere wichtige Antibiotika erworben haben (Multiresistenz), sind sie besonders schwer zu eliminieren und werden bei Übertragung auf Dritte auch für diese zur Gefahr.
Bei Menschen und Tieren ist Staphylococcus aureus einer der wichtigsten Verursacher von Brustdrüsenentzündung (Mastitis).[3]
Pathomechanismen


Staphylococcus aureus besitzt zahlreiche Pathogenitätsfaktoren, darunter eine Polysaccharidkapsel mit Protein A, die das Bakterium vor Aufnahme in Makrophagen (Phagozytose) schützt. Das Protein A bindet Antikörper an deren Fc-Fragment, also genau „verkehrt herum“ und damit anders, als es für eine effektive Opsonierung notwendig wäre. Dadurch erkennen Makrophagen den Fc-Teil nicht und eine Aufnahme und Zerstörung unterbleibt. Staphylococcus aureus ist ein fakultativ intrazellulärer Erreger und kann mittels Fibronektin bindender Proteine indirekt an Integrin α5β1 binden und über einen Zipper-Mechanismus in die Wirtszelle eindringen. Dies ist einerseits wichtig für die Erregerpersistenz als auch bei der Entstehung invasiver Krankheitsbilder wie Endokarditis, Sepsis und Mastitis.[4]
Die Koagulase und der Clumping-Faktor A bewirken eine lokale Gerinnung von Fibrin und damit die Ausbildung eines Fibrinwalls, mit dem Staphylococcus aureus sich umkleidet und von Antikörpern nun nicht mehr erkannt wird. Der Clumping-Faktor ist ein auf der Zelloberfläche befindlicher Fibrinogenrezeptor. Erst wenn sich das Bakterium stark vermehrt hat, wird mit Hilfe von Staphylokinase Fibrinolysin gebildet und der Wall aufgebrochen. Mittels der bakteriellen Enzyme Hyaluronidase, DNase, Lipase und den Hämolysinen ist es nun im Stande, interzelluläres Bindegewebe und Parenchymzellen zu lysieren und invasiv in den Wirtsorganismus vorzudringen. Leukozidin hilft dabei, die zellulären Bestandteile der Immunantwort (Granulozyten und Makrophagen) zu schädigen. Auf diesem Wege verursacht Staphylococcus aureus pyogene (eitrige) Infektionen, die lokal-oberflächlich (beispielsweise Furunkel, Karbunkel) auftreten können, aber auch schwere tiefe, systemische Prozesse (Osteomyelitis, Pneumonie, Endokarditis, Abszesse, Empyeme, Sepsis) mit hoher Letalität bedingen können.
Die Koagulase und der Clumping-Faktor werden zum Nachweis von Staphylococcus aureus herangezogen.
Staphylococcus aureus kann mehrere Toxine produzieren, die zu verschiedenen typischen Erkrankungen führen:
- Enterotoxine sind Superantigene. Da sie sehr hitzebeständig sind und durch Kochen nicht zerstört werden, spielen sie eine große Rolle bei Lebensmittelvergiftungen (Durchfall, Erbrechen mit kurzer Inkubationszeit von wenigen Stunden).
- Exfoliatine A und B (in etwa 5 % der Staphylococcus-aureus-Isolate vorhanden) sind neben der Invasion der Bakterien beteiligt am Staphylococcal Scalded Skin Syndrom (Morbus Ritter von Rittershain, Pemphigus neonatorum oder Syndrom der verbrühten Haut: Blasenbildung im Bereich der Haut, Rötung, Juckreiz, Lethargie, Fieber oder Hypothermie, Schleimhäute nicht mitbetroffen (im Gegensatz zum Lyell-Syndrom), Blasen ohne Erreger, hauptsächlich bei Kleinkindern und immunsupprimierten Erwachsenen über 60 Jahre, Therapie: symptomatisch: Flüssigkeit, Haut wie bei Brandverletzten (ITS), Clindamycin als Antibiotikum der Wahl)
- TSST-1 (Toxic-Shock-Syndrom-Toxin-1): Verursacht das Toxic Shock Syndrome. Das Toxin wirkt als Superantigen und bewirkt eine polyklonale CD4-T-Zell-Aktivierung mit unkoordinierter Freisetzung von Zytokinen. Dies führt zu Exanthemen, Hypotonie, Fieber, Schock, Multiorganversagen, selten auch zum Tod. Eintrittspforte der TSS-Erreger kann prinzipiell jede eitrige Wunde sein, hinter einem Teil der Infektionen werden jedoch Tampons vermutet, auf denen sich Staphylokokken oder Streptokokken angesiedelt haben. Obwohl das Risiko eines durch Tampons verursachten TSS gering ist, sollten Tampons alle vier bis acht Stunden gewechselt werden.[5]
- Panton-Valentine-Leukocidin: nekrotisierende Pneumonien mit hoher Letalität.[6]
- α-Hämolysin: ein porenbildendes Toxin
Des Weiteren wurden viele kleine bakterielle RNAs in S. aureus gefunden, welche an der Pathogenität beteiligt sind. Sie sind an der Adaption des Stoffwechsels des Bakteriums beteiligt, um es an verschiedene Umgebungen anzupassen.[7] Des Weiteren sind sie an einer verstärkten Biofilm-Formation mit der Folge von Pathogenität beteiligt.[8] Beispiele dieser kleinen RNAs wären: RNAIII[9], SprD[10], SprC[11][12], RsaE[13], SprA1[14], SSR42[15], ArtR[16], SprX und Teg49.[17]
Staphylococcus aureus zählt zu den wichtigsten Erregern von im Krankenhaus erworbenen (nosokomialen) Infektionen. Der Erreger kann jedoch auch über die Haut oder Schleimhaut von Mensch und Tier aufgenommen werden. Durch Husten oder Niesen besteht die Möglichkeit der Übertragung auf Lebensmittel.
Das Bakterium ist äußerst widerstandsfähig gegen Austrocknung und kann zusätzlich eine Reihe von Resistenzen gegenüber Antibiotika aufweisen.
Multiresistenz
Klassifikation nach ICD-10 | |
---|---|
U83.7[20] | Resistenz gegen mehrere Antibiotika |
ICD-10 online (WHO-Version 2019) | |
Klassifikation nach ICD-10-GM | |
U80.00! | Staphylococcus aureus mit Resistenz gegen Oxacillin oder Methicillin [MRSA] |
ICD-10 online (GM-Version 2024) |


Gebräuchliche Abkürzungen:
- MRSA = Methicillin-resistenter Staphylococcus aureus. Fälschlicherweise ist zusätzlich die Bezeichnung Multi-resistenter Staphylococcus aureus als Bezeichnung für S.-aureus-Keime gebräuchlich. Bei MRSA handelt es sich um Stämme mit einer Resistenz gegen (das nicht mehr als Arzneimittel im Handel befindliche) Methicillin.[18]
- MRE = Multi-resistente Erreger
- ORSA = Oxacillin-resistenter Staphylococcus aureus
- VISA = Vancomycin-intermediate Staphylococcus aureus
- VRSA = Vancomycin-resistenter Staphylococcus aureus
Unter MRSA (auch als ORSA bezeichnet) versteht man im engeren Sinne Staphylococcus-aureus-Stämme, die gegen alle bisher marktverfügbaren β-Lactam-Antibiotika (z. B. Penicillin) resistent sind. Sie sind allerdings in der Regel multiresistent, verfügen also meist auch über Resistenzen gegenüber anderen Antibiotikaklassen, so gegen Chinolon-Antibiotika, Tetracycline, Aminoglykoside, Erythromycin, Sulfonamide. VISA besitzen zusätzlich eine verminderte Empfindlichkeit gegenüber Vancomycin und anderen Glykopeptidantibiotika. Die wenigen bisher beschriebenen VRSA-Stämme sind resistent gegenüber Vancomycin und anderen Glykopeptidantibiotika.
Methicillin wurde historisch für den Antibiotika-Sensitivitätstest von Bakterien eingesetzt (MSSA = Methicillin-sensitiver Staphylococcus aureus). Eine Therapie erfolgt im positiven Fall meist mit Vancomycin Daptomycin oder Linezolid. Die Behandlung sollte sich am Antibiogramm orientieren, denn auch gegen Vancomycin sind schon Resistenzen aufgetreten (VRSA).
Methicillin und Oxacillin gehören zu den Penicillinase-stabilen Penicillinen. In Deutschland wird Oxacillin in der Tiermedizin eingesetzt, in der Humanmedizin das Oxacillin-Derivat Flucloxacillin. Weitere Vertreter dieser Stoffklasse sind Cloxacillin, Dicloxacillin und Nafcillin (in den USA verwendet). Methicillin wird nicht mehr zur Therapie verwendet.
Antibiotikum | R | I | S | Total | ||||
---|---|---|---|---|---|---|---|---|
n | % | n | % | n | % | n | ||
Oxacillin | 8147 | 17,6 | 0 | 0,0 | 38231 | 82,4 | 46378 | |
Penicillin | 32852 | 75,7 | 0 | 0,0 | 10537 | 24,3 | 43389 | |
Ciprofloxacin | 8692 | 29,6 | 73 | 0,2 | 20609 | 70,2 | 29374 | |
Levofloxacin | 12982 | 27,6 | 130 | 0,3 | 33855 | 72,1 | 46967 | |
Moxifloxacin | 7046 | 26,5 | 377 | 1,4 | 19159 | 72,1 | 26582 | |
Gentamicin | 1066 | 2,2 | 5 | 0,0 | 47975 | 97,8 | 49046 | |
Clindamycin | 11037 | 22,5 | 27 | 0,1 | 37890 | 77,4 | 48954 | |
Erythromycin | 11538 | 23,6 | 34 | 0,1 | 37338 | 76,3 | 48910 | |
Doxycyclin | 740 | 4,2 | 5 | 0,0 | 16840 | 95,8 | 17585 | |
Tetracyclin | 1283 | 4,3 | 149 | 0,5 | 28588 | 95,2 | 30020 | |
Teicoplanin | 33 | 0,1 | 0 | 0,0 | 37666 | 99,9 | 37699 | |
Co-Trimoxazol | 599 | 1,2 | 13 | 0,0 | 48511 | 98,8 | 49123 | |
Fosfomycin | 592 | 1,4 | 0 | 0,0 | 41487 | 98,6 | 42079 | |
Fusidinsäure | 1018 | 2,6 | 74 | 0,2 | 37586 | 97,2 | 38678 | |
Rifampicin | 200 | 0,5 | 61 | 0,1 | 41447 | 99,4 | 41708 | |
R=resistent; I=intermediär; S=sensitiv; n=Anzahl Isolate |
Erstmals beschrieben wurden MRSA Anfang der 1960er Jahre in Großbritannien.[21][22]
In Deutschland bekannt wurden sie auch durch den Fernseh-Dokumentarfilm Tatort Krankenhaus von Tilman Wolff. Darin wurde 2008 verdeutlicht, dass in deutschen Krankenhäusern jährlich bei etwa 160.000 Menschen eine MRSA-Besiedelung festgestellt wird und dass es im Klinikalltag vielfach an elementaren Hygienemaßnahmen wie Händewaschen mangelt.[23]
Neben diesen typischen Krankenhaus-assoziierten MRSA werden seit einigen Jahren auch MRSA beschrieben, die Personen außerhalb von Einrichtungen des Gesundheitswesens besiedeln, sogenannte community acquired (dt. ‚ambulant erworbene‘) MRSA.
Eine dritte Gruppe stellen die nutztierassoziierten (englisch livestock associated) MRSA dar, die bei praktisch allen Nutztierarten gefunden werden können, insbesondere bei Schweinen, Mast-Kälbern und Mast-Puten. Diese Stämme besiedeln nicht nur die Tiere, sondern häufig auch ihre Betreuer. Bei der Schlachtung können die Bakterien auf das Fleisch übertragen werden, was häufig bei Hähnchen- und Putenfleisch festgestellt wird. Allerdings scheint dieser Umstand nicht zur Verbreitung von LA-MRSA in der Bevölkerung beizutragen.[24] 2011 wurden in einer Studie in den USA in Geflügelfleisch Erreger nachgewiesen, die gegen neun Antibiotika resistent waren.[25][26]
Mechanismus der Resistenz
Gegen Antibiotika resistente Erreger kommen vermehrt dort vor, wo ständig Antibiotika verwendet werden. Die Antibiotika töten zwar fast alle Individuen der Erreger ab, aber einige wenige können überleben, weil sie aufgrund einer Mutation gegen das angewendete Antibiotikum resistent sind. Diese resistenten Individuen vermehren sich dann trotz der Antibiotika-Therapie weiter – eine klassische Selektion im evolutionsbiologischen Sinne. Die Resistenz vermittelnden Gene werden dabei auch artübergreifend weitergegeben, zum Beispiel von Staphylococcus aureus zu anderen Arten, siehe auch Horizontaler Gentransfer.[27] Die Entstehung von Resistenzen gegen Antibiotika wird allerdings auch durch die Verwendung von Reinigungsmitteln, die sogenannte quartäre Ammoniumverbindungen (QAV) mit desinfizierender Wirkung enthalten, begünstigt. Denn dieselben Gene der Bakterien, welche die QAV-Resistenz liefern, vermitteln ihnen auch die Resistenz gegen Antibiotika.[27] Zu den insofern kritischen Stoffen gehören die meisten marktüblichen kationischen Tenside. Ähnliches gilt für Triclosan, das als Desinfektions- und Konservierungsstoff in Haushaltsreinigern, Waschmitteln, Zahnpasten, Deodorantien und Seifen enthalten ist.
MRSA besitzen das Resistenzgen mecA (selten auch mecC), das für ein modifiziertes Penicillin-Bindeprotein (PBP2a, syn. PBB2') kodiert. Dieses Protein – die bakterielle Transpeptidase – ist normalerweise für die korrekte Verknüpfung der Bausteine der Zellwand verantwortlich. β-Lactam-Antibiotika imitieren einen solchen Baustein, binden aber irreversibel an die Transpeptidase, welche dadurch dauerhaft inaktiviert wird. Wenn genügend Transpeptidasen auf diese Weise zerstört werden, können keine neuen Verknüpfungen mehr gebildet werden und die Zellwandsynthese kommt zum Erliegen, β-Lactam-Antibiotika wirken deshalb nur auf wachsende Zellen.
Der phänotypische Nachweis auf das Vorliegen eines Resistenzgens sowohl vom Typ mecA wie auch mecC, kann mittels eines Cefoxitin-Screens erfolgen.[28]
β-Lactam-Antibiotika können an das modifizierte Penicillin-Bindeprotein nicht mehr binden, dieses kann ungehindert weiter bei der Zellwandsynthese helfen. Das führt dazu, dass MRSA gegen alle β-Lactam-Antibiotika (Penicilline, Cephalosporine und Carbapeneme) resistent sind. Charakteristisch für MRSA war bis vor kurzem, dass sie auch gegen weitere Antibiotikaklassen (beispielsweise Tetracycline, Aminoglykoside, Makrolide) Resistenzen erworben haben und damit eine Multiresistenz aufweisen. Seit wenigen Jahren beobachtet man zusätzlich eine neue Gruppe von MRSA, die diese Multiresistenz nicht aufweisen und als sogenannte community-acquired MRSA (auch community onset MRSA) bezeichnet werden.
Ein weiterer Resistenzmechanismus gegen β-Lactame, der aber nicht nur bei den MRSA anzutreffen ist, beruht auf der Bildung eines Enzyms, das Penicillin abbauen kann (Betalactamase).
Allerdings sind auch Infektionen mit nicht resistenten Staphylococcus-Stämmen, etwa im Mittelohr oder in den Atemwegen, häufig nur sehr schwer mit Antibiotika zu bekämpfen. Diese Infektionen neigen dazu, chronisch zu werden, das heißt, sie flammen immer wieder auf. Offenbar sind diese Bakterien in der Lage, in Körperzellen einzudringen.[29] Dort fahren die Krankheitserreger ihren Stoffwechsel stark herunter. Durch den Einschluss in Körperzellen dem Immunsystem des Wirts entzogen und durch Absenkung des Stoffwechsels geschützt vor Antibiotika, können sie so Tage bis möglicherweise Wochen ausharren, um anschließend ihren Stoffwechsel wieder hochzufahren, sich zu vermehren und sich erneut auszubreiten.
Eine weitere Rolle bei der Resistenzbildung spielen polymikrobielle Biofilme. So fand man in Studien nicht nur, dass Staphylococcus aureus zusammen mit der Hefe Candida albicans starke Biofilme bilden kann, sondern auch, dass die von den Pilzen abgesonderte Matrix eine Vancomycin-undurchlässige Schutzschicht darstellt.[30] So gelang das Abtöten der Staphylokokken unter Zugabe eines Biofilmlösers. Neben einigen Antimykotika (z. B. Amphotericin-B) sind auch einige NSAR in der Lage, Candida-Biofilme „aufzubrechen“ und somit Staphylokokken wieder zugänglich für Antibiotika zu machen.[31] Biofilme sind nicht nur ein Problem bei der Behandlung mit Antiinfektiva, sondern stellen auch ein Hindernis für das Immunsystem des Patienten dar.[32]
Verbreitung von MRSA

International
Auffallend sind die großen Unterschiede in der Häufigkeit des Auftretens von MRSA in verschiedenen Staaten, die ansonsten etwa gleiche Niveaus in ihren Gesundheitswesen aufweisen. Hierbei ist zu beachten, dass die vom EARS-Net im Auftrag des Europäischen Zentrums für die Prävention und die Kontrolle von Krankheiten (ECDC) gesammelten und veröffentlichten Daten (siehe Abbildung) die Ergebnisse von Routinetests in klinischen Laboratorien über die Antibiotikaempfindlichkeit darstellen. Dabei werden nur Daten von invasiven Isolaten (Blut und Liquor cerebrospinalis) erfasst.[34] Während in den skandinavischen Ländern der Anteil von MRSA in Krankenhäusern unter den Staphylococcus-aureus-Stämmen gering ist und in den Niederlanden bei ca. 3 % liegt, beträgt die MRSA-Rate in Deutschland etwa 25 %,[35] wobei es – vermutlich je nach Krankenhaushygiene – starke lokale Unterschiede gibt (bis über 50 %). In den südeuropäischen Ländern, den USA sowie in vielen asiatischen Ländern (Japan) liegen die Werte sogar bei 30 bis über 70 %. Auch in Alten- und Pflegeheimen, Gefängnissen, ambulanten Diensten, öffentlichen Duschen und dergleichen finden sich MRSA.
Außerhalb von Kliniken
Zum ersten Mal beschrieben wurden Methicillin-resistente Staphylococcus-aureus-Stämme 1993 bei australischen Ureinwohnern, die nie Kontakt zum Gesundheitswesen hatten.[36] Ende der 1990er Jahre wurden solche Stämme zum ersten Mal in den USA beobachtet. Seither haben ambulant erworbene MRSA-Besiedelungen stetig an Bedeutung gewonnen.
MRSA werden zunehmend auch außerhalb von Krankenhäusern gefunden. Im englischsprachigen Schriftgut werden diese Erreger als Community-acquired methicillin-resistant Staphylococcus aureus (cMRSA oder caMRSA bzw. CA-MRSA) bezeichnet. Darunter gibt es viele Stämme wie den Pulsed-Field Gelelektrophorese (PFGE)-Typ USA300 (entspricht dem Multi Locus Sequence Typing (MLST)-Typ ST 8) mit besonders aggressivem Verhalten, die das sogenannte Panton-Valentine-Leukozidin-Toxin aufweisen (PVL-MRSA) und vorwiegend ambulant erworbene rezidivierende Infektionen der Haut und Weichgewebe (Furunkel, Karbunkel, Impetigo) sowie lebensbedrohliche Infektionen wie Sepsis oder nekrotisierende Lungenentzündungen[37] verursachen können.
In manchen Regionen der USA wurde CA-MRSA in der Mehrzahl schwerer Haut- und Weichteilinfektionen nachgewiesen. Im Gegensatz zu nosokomialen MRSA-Stämmen spricht CA-MRSA oft auf die Therapie mit einigen nicht-β-Lactam-Antibiotika an.[38]
Nach einer französischen Studie schleppen viele Patienten, die sich im Krankenhaus infiziert haben, diese Bakterien nach ihrer Entlassung in ihre Wohnungen ein.[39]
Landwirtschaft, industrielle Nahrungsmittelproduktion
In einer internationalen Studie wurde die Rate kolonisierter Schweinezuchtarbeiter mit 12 % bestimmt, wobei Schutzkleidung offensichtlich keinen Nutzen hatte.[40]
Bei einer Untersuchung des Landesgesundheitsamts Niedersachsen 2011 waren 21 % der gefundenen MRSA aus der Landwirtschaft in die menschlichen Körper gelangt.[41]
Außerhalb vom Menschen
In den USA wurden 2009 an fünf von zehn untersuchten öffentlichen Meeresstränden in den Bundesstaaten Kalifornien und Washington MRSA gefunden;[42] vor den Olympischen Sommerspielen 2016 in Brasilien an fünf Stränden vor Rio de Janeiro[43]
Über Gülle gelangen MRSA in die Böden von landwirtschaftlich genutzten Feldern: In geringen Konzentrationen konnten sie bereits in Feldfrüchten nachgewiesen werden. Sie können Monate bis Jahre weiter aktiv sein: Aktuell in den Niederlanden untersuchtes Erdreich weist im Vergleich zu Böden, die 1940 archiviert wurden (als es kaum Antibiotika gab) 15-mal so viele Resistenzgene auf. Bäche bzw. Flüsse, die gereinigte Kläranlagen-Abwässer oder ausgeschwemmtes Material aus der Landwirtschaft aufnehmen müssen, wiesen in Proben aus mehreren Jahren des Karlsruher Institut für Technologie (KIT) die zweithöchste Belastung auf. Auch in Regenklär- und Überlaufbecken, im Sickerwasser von Deponien und in geringen Spuren im Grundwasser finden sich MRSA.[41]
Klärwerke, Klärschlamm
Im Klärschlämmen verschiedener Regionen Englands wurden resistente Stämme von Staphylococcus aureus nachgewiesen.[27]
Proben über mehrere Jahre aus Gewässern, Grundwassermessstellen, Klärwerken, Klinikabwässern oder Regenüberlaufbecken des Karlsruher Institut für Technologie (KIT) zeigten die höchste MRSA-Belastung bei Abwässern von Kliniken und Kläranlagen.[41]
In Tieren
MRSA sind auch nicht auf Menschen beschränkt. 2007 wurden bei einer Studie in kanadischen Schweinefarmen MRSA gefunden. Menschen waren in der Hälfte dieser 20 Farmen kolonisiert, Schweine in einem Viertel. Die genetische Information der Bakterien war jeweils identisch, was eindeutig auf eine Übertragung zwischen Mensch und Tier hinweist.[44]
Schon früher ist man auch in den Niederlanden auf MRSA in der Schweinemast gestoßen. Es hat sich dort gezeigt, dass in Betrieben, in denen Schweine routinemäßig mit Antibiotika behandelt wurden, 60 % der Schweine mit MRSA kolonisiert waren. In Betrieben, in denen die Schweine nicht routinemäßig Antibiotika erhielten, waren nur 5 % mit MRSA besiedelt.[45]
Bei einer weiteren niederländischen Studie waren 41 % von 540 Schlachtschweinen MRSA-kolonisiert. Auch im Rahmen des Viehhandels sowie des Schlachtvorganges können die Bakterien verschleppt und dann in Lebensmitteln von entsprechenden Tieren nachgewiesen werden, so in Puten-, Hähnchen- oder Kalbfleisch sowie in Rohmilch.[46]
In Einrichtungen der Alten- und Krankenversorgung
MRSA stellen weltweit vor allem in Kliniken eine Gefahr dar. Besonders betroffen sind die operativen Intensivstationen, Abteilungen für Brandverletzungen und Neugeborenenstationen.
Der Anteil von Personen mit MRSA zu nicht betroffenen Personen (Prävalenz) bei Bewohnern von Altenheimen und Patienten von Reha- und Akutkliniken lag z. B. 2008 im Kreis Höxter zwischen 1,2 und 3,4 %.[47] In Deutschland infizieren sich etwa 50.000 Patienten je Jahr mit MRSA. In manchen Kliniken beruhen bis zu 30 % der dort erworbenen Infektionen auf MRSA.
Eine unbekannte Anzahl von Patienten ist schon bei der Aufnahme in die Klinik kolonisiert, ohne es zu wissen. Hier kann nur eine Eingangsuntersuchung Klarheit verschaffen, wie sie z. B. in den Niederlanden durchgeführt wird.
Nach Angaben der Techniker Krankenkasse Schleswig-Holstein ist die Zahl der MRSA-Erkrankungen in den Kliniken dieses Bundeslandes von 2006 bis 2009 um 192 % gestiegen (von 191 auf 557 Fälle). Die Zunahme in anderen Bundesländern lag bei teilweise über 200 %.[48]
2011 wurden im Rahmen einer Untersuchung des Landesgesundheitsamts Niedersachsen bei knapp 2,6 Prozent der Untersuchten MRSA nachgewiesen (127 Abstriche von knapp 5.000 Patienten aus 33 Kliniken).[41]
Todesfälle durch MRSA
In den USA starben im Jahr 2005 etwa 19.000 Menschen allein an Infektionen mit MRSA.[49]
Für Deutschland gehen die Schätzungen der Todesfälle durch im Krankenhaus erworbene Infektionen weit auseinander, von jährlich etwa 1.500 Todesopfern[50] bis zu etwa 40.000.[51] Auch die Deutsche Gesellschaft für Krankenhaushygiene schätzte 2009 etwa 40.000 Todesfälle jährlich durch in deutschen Krankenhäusern zugezogene Infektionen.[52] Das wäre deutlich mehr als die durchschnittliche jährliche Übersterblichkeit durch die saisonale Influenza. Die ungenauen Angaben liegen unter anderem darin begründet, dass MRSA in Deutschland – anders als beispielsweise in Großbritannien – nicht im Totenschein als Diagnose vermerkt wird. Es müsste zudem vor allem unterschieden werden, ob die MRSA-Infektion tatsächlich todesursächlich war oder nur eine klinisch unbedeutende Infektion bzw. Kolonisation mit MRSA bestand. 2014 bekräftigte die DGKH ihre Schätzung der Zahl der jährlichen Todesfälle durch Krankenhausinfektionen auf 40.000; die Hälfte davon seien durch Hygienemaßnahmen vermeidbar und insgesamt werde die Zahl der Infektionen deutlich unterschätzt.[53]
Ein MRSA-Trägerstatus erhöht in Deutschland das Risiko, bei einem Klinikaufenthalt zu sterben, um den Faktor 2,7.
Therapie bei Multiresistenz
Infektionen mit MRSA werden mit so genannten Reserveantibiotika wie Vancomycin und neuerdings Linezolid, Daptomycin, Tigecyclin oder einer Kombination aus Quinupristin mit Dalfopristin behandelt. Letztere sind auch gegen vancomycinresistente Staphylococcus aureus wirksam, Linezolid kann auch oral verabreicht werden. Nachdem es im Zusammenhang mit Linezolid-Anwendung zu erhöhter Sterblichkeit kam,[54] gelten Tigecyclin, Daptomycin neben Vancomycin als Mittel der Wahl. Allerdings gestaltet sich im klinischen Alltag die Therapie von Patienten mit MRSA-Infektionen oft schwierig und langwierig. Bei manchen Patienten, die bereits auf dem Weg der Besserung sind, ist es möglich, die Antibiotikabehandlung zu beenden. Dann kann sich auch die normale Mikroorganismengesellschaft von Haut- und Schleimhaut regenerieren und verdrängt die MRSA wieder.
Sanierung
Bei der Sanierung werden MRSA-belastete Körperstellen oder Wunden dekolonisiert. Durch Reinigung und Desinfektion mit speziellen bakteriziden Präparaten (z. B. octenidinhaltige Waschlotion) werden die Erreger mechanisch entfernt bzw. abgetötet. Weitere Hygienemaßnahmen sind täglicher Wechsel von Bett- und Körperwäsche sowie Handtüchern und Waschlappen.[55][56] Bei einer Kolonisation der Nase kommt die Anwendung von Mupirocin-Salbe in Betracht, bei einer des Rachens das Gurgeln mit antiseptischen Lösungen wie Chlorhexidin.[57]
Suche nach Alternativen und neuen bzw. veränderten Antibiotika
Eine gemeinsame Forschergruppe der Universitäten Bonn und Düsseldorf, gefördert von der Deutschen Forschungsgemeinschaft, zeigte in verschiedenen Studien, dass Acyldepsipeptide (ADEPs) gegen grampositive Bakterien wirken, darunter auch Staphylococcus aureus. Während herkömmliche Antibiotika bestimmte Reaktionen in Bakterienzellen hemmen, greifen die Acyldepsipeptide (ADEPs) an einer anderen Schlüsselstelle in den Stoffwechsel der Bakterien ein. Sie führen zu einer Fehlsteuerung eines wichtigen Enzyms. Die Zellteilung und dadurch die Vermehrung der Erreger wird verhindert.[58]
Bei Gabe von Medikamenten zur Senkung des Cholesterinspiegels wurde Staphylococcus aureus empfindlicher gegenüber Desinfektionsmitteln, da die Cholesterinbiosynthese mit der Synthese des gelben Schutzpigments Staphyloxanthin verwandt ist.[59] Aktuelle japanische Studien haben ergeben, dass ein verwandtes Bakterium, Staphylococcus epidermidis, ein Enzym bildet, das den Biofilm des Staphylococcus aureus zerstören und Bildung neuer Biofilme verhindern soll.[60]
Extrakte verschiedener Pflanzenarten zeigen in-vitro (d. h. außerhalb eines lebenden Organismus) teilweise hohe Aktivität gegen multiresistente MRSA mit mehreren Resistenzen, dazu gehört der Blättertee der Kastanie. In den Pflanzenextrakten konnten Phenole und Flavonoide als Träger der antimikrobiellen Aktivität festgestellt werden.[61] Knoblauch (Allium sativum) und Orange (Citrus sinensis) sind wenig aktiv. Indisches Basilikum, Sesamöl und Sojabohnenöl sind in-vitro moderat wirksam.[62][63] Dem Öl der Himalaya-Sorte von Oregano (Oreganum vulgare) wurde 2008 eine antimikrobielle Wirkung gegen MRSA nachgewiesen. In in-vitro-Tests zeigte es eine höhere Effektivität als 18 andere als antibiotisch wirksam bekannte Stoffe. Die antimikrobielle Wirkung des Öls der mediterranen Sorte war bereits zuvor bekannt. Die Wirkung ist bedingt durch den Gehalt an Carvacrol.[64][65]
Um die ungebremste Kontamination z. B. via Landwirtschaft und (Klinik-)Abwässer in die Umwelt zu verringern, könnten Antibiotika eine „Sollbruchstelle“ enthalten, um einen raschen Abbau zu gewährleisten.[41]
Bakteriophagen könnten eine Behandlungsoption gegen multiresistente Bakterien bieten. Aktuelle Erfahrungen mit der Phagentherapie gibt es bislang nur in der ehemaligen Sowjetunion[66] und Polen.[67]
Forscher der ETH Zürich haben ein Endolysin entwickelt, Staphefekt SA.100, welches nur das Bakterium Staphylococcus aureus tötet, sowie MRSA.[68]
Im Juli 2016 wurde berichtet, dass in der Nasenflora des Menschen ein Bakterium – Staphylococcus lugdunensis – gefunden wurde, das MRSA abtöten könne. Der gefundene Wirkstoff wurde Lugdunin genannt und sollte auf Verträglichkeit mit dem Menschen untersucht werden.[69]
Vorsorge
Kliniken und Krankenhäuser

Das Auftreten von MRSA-Stämmen im Krankenhaus erfordert gezielte anti-epidemische Maßnahmen mit Isolierung des Patienten oder mehrerer mit MRSA besiedelten Patienten in einem Zimmer (Kohortenisolierung). Da die Erreger im Krankenhaus meist von Pflegepersonal und Ärzten (iatrogen) verbreitet werden, ist die wichtigste Maßnahme gegen die Ausbreitung multiresistenter Erreger die gründliche Händedesinfektion. Je nach der zu verrichtenden Tätigkeit am Patienten oder der Lokalisation des MRSA beim Patienten werden zusätzlich Einmalhandschuhe, Schutzkittel und Mundschutz getragen. Die strikte Einhaltung der Händehygiene ist der wichtigste Teil der Vorsorge. Führungskräften kommt dabei eine wichtige Vorbildfunktion zu.[70] Isolierungsmaßnahmen können die Übertragungsrate in Krankenhäusern deutlich verringern.[71]
Vom Robert Koch-Institut (RKI) werden Screening-Untersuchungen in Krankenhäusern bisher nur für bestimmte Gruppen empfohlen:
- Bei Patienten mit beispielsweise chronischer Pflegebedürftigkeit, liegenden Kathetern, chronischen Wunden
- Beim Krankenhauspersonal bei Ausbruch, d. h. bei gehäuftem Nachweis von MRSA bei mehr als zwei Patienten, die in einem räumlichen und zeitlichen Zusammenhang stehen, und bei nachgewiesener klonaler Identität des MRSA.
Dagegen hielt das RKI 2009 das Screening aller zur Aufnahme kommenden Patienten und des gesamten Personals für zu aufwändig, und das Gesundheitsministerium des Bundes verwies auf die Zuständigkeit der Länder.[51] So hat das Bayerische Landesamt für Gesundheit und Lebensmittelsicherheit Ende 2009 eine Landes-Arbeitsgemeinschaft Multi-Resistente Erreger (LARE) eingerichtet, die auch eine Telefon-Hotline und Website unterhält.[72]
In Deutschland haben nur fünf Prozent der deutschen Kliniken einen Hygienearzt – mit sinkender Tendenz. In den Niederlanden hingegen umfassen die Schutzmaßnahmen das Screening aller zur Aufnahme kommenden Patienten, den Einsatz eines Hygienefacharztes in jeder Klinik und die Abstimmung jeder Antibiotika-Behandlung mit einem Mikrobiologen. Hierunter kam es zu einer massiven Absenkung der MRSA-Prävalenz mit einer Häufigkeit von 20 % der im benachbarten Deutschland auftretenden Fälle.[73] Auch ist die Häufigkeit von MRSA des benachbarten Raums Münster gesunken, nachdem dort seit 2006 in über 40 Kliniken im Rahmen des Euregio-Projektes MRSA-net ein Verfahren ähnlich dem niederländischen eingeführt wurde.[74]
Experten halten ein ähnliches Vorgehen für den Rettungsdienst und Krankentransport für sinnvoll. Da viele Patienten, die in klinischer Behandlung waren, Träger von MRSA sind, ohne es zu wissen oder die entsprechenden Symptome zu zeigen, sollte das Rettungsfachpersonal die Anamnese auch auf solche Krankheiten hin betreiben. Der Transport eines MRSA-positiven Patienten erfordert vom Rettungsfachpersonal das Tragen von Schutzkleidung und Einmalhandschuhen sowie eine Schlussdesinfektion des kompletten Fahrzeugs. Hierbei steht nicht der Schutz des Personals im Vordergrund (eine Kolonialisation mit MRSA bleibt für Gesunde in der Regel folgenlos), sondern eine Eindämmung der Verbreitung von MRSA, da der Rettungs- bzw. Krankentransportdienst durch die hohe Zahl von Patientenkontakten und den häufigen Aufenthalt in Kliniken einen wirksamen Vektor darstellt.[75] Dies zusätzlich deshalb, weil bisher bei der Entlassung von kolonisierten Patienten eine Dekolonisierung ausbleibt, da deren Kosten bis heute nicht von den Krankenkassen getragen werden.[70]
Zum 1. Januar 2011 sollte in Baden-Württemberg eine neue Hygieneverordnung für Kliniken, Vorsorge- und Rehabilitationseinrichtungen eingeführt werden, um die Anzahl der Klinikinfektionen einzudämmen und eine landeseinheitliche Systematik für die Infektionsprävention zu schaffen.[76][77] Es war geplant, ein effizientes Hygienemanagement einzurichten und die Erstellung von Hygieneplänen sowie die Benennung von Ansprechpersonen und Beauftragten, welche sich um die Einhaltung von Vorschriften kümmern sollen, verbindlich zu regeln. Die VO ist als „Verordnung über die Hygiene und Infektionsprävention in medizinischen Einrichtungen“[78] am 31. Juli 2012 in Kraft getreten. In § 4 der Verordnung ist die Einrichtung von Hygienekommissionen geregelt, welche u. a. „in Krankenhäusern Empfehlungen erarbeiten, wie nosokomiale Infektionen, das Auftreten von Krankheitserregern mit speziellen Resistenzen und Multiresistenzen sowie der Antibiotikaverbrauch aufzuzeichnen sind, diese Aufzeichnungen bewerten und sachgerechte Schlussfolgerungen für Maßnahmen der Hygiene und Infektionsprävention sowie den Einsatz von Antibiotika ziehen“. Die Aufgaben der Hygienefachkräfte sind in § 6 der VO geregelt, Hygienepläne sind in § 2 Absatz 4 der VO angesprochen. Ähnlich strukturiert ist die Verordnung über die Hygiene und Infektionsprävention in medizinischen Einrichtungen,[79] die in Nordrhein-Westfalen seit dem 31. März 2012 gilt. Bayern hat schon länger die Verordnung zur Hygiene und Infektionsprävention in medizinischen Einrichtungen;[80] ähnliche Verordnungen gibt es auch in Bremen, Hamburg und Sachsen.
Zusammenfassend können Neuentstehung und Ausbreitung von MRSA durch drei Vorgehensweisen bekämpft werden:
- Durch den rationellen und erregerorientierten Einsatz von Antibiotika sowie durch deren Nichtanwendung, falls es nicht erforderlich ist (beispielsweise bei leichteren Virusinfektionen der Atemwege ohne größere Gefahr der Zweitinfektion mit Bakterien)
- Durch konsequentes Umsetzen von (vorbeugenden) Hygienemaßnahmen im Krankenhaus
- Durch Screening aller Patienten sofort bei der Aufnahme im Krankenhaus mit Isolierung und Sanierung betroffener Patienten, wie es weiter oben unter „Niederlande“ beschrieben wurde. Ein Kostenvergleich des niederländischen Systems mit dem in Deutschland bislang vorherrschenden sollte inzwischen möglich sein. Trotzdem wären Kosten allein nicht relevant, da die Vermeidung von Todesfällen und schweren Komplikationen selbstverständlich Vorrang hat.
Psychosoziale Effekte einer MRSA-Besiedelung wurden in Deutschland bisher (März 2010) „völlig unzulänglich erforscht“.[81]
Häuslicher Bereich
Im häuslichen Bereich sollen die üblichen konservativen Hygienemaßnahmen eingehalten werden, d. h. ohne die Verwendung von Desinfektionsmitteln (siehe oben: Resistenzbildungen eben durch Desinfektionsmittel). Fleisch sollte nicht roh verzehrt und insbesondere Kleinkindern keine rohe Milch zu trinken gegeben werden.[46]
Speisenzubereitung und Küchenhygiene
Vermeidung von Verunreinigungen von Speisen bei der Zubereitung durch nachfolgende Maßnahmen:
- Haustiere von Lebensmitteln fernhalten, während der Speisenzubereitung nicht streicheln
- vor Arbeitsbeginn auf persönliche Hygiene achten (saubere Kleidung, saubere Hände und Fingernägel, ggf. Kopfhaar zusammenbinden und Handschmuck ablegen).
- Das Berühren der Lebensmittel mit Mund, Nase und Haaren vermeiden.
- Falls möglich, Lebensmittel besser mit sauberem Besteck als mit den Händen zubereiten.
Sofern ausreichend Kühlkapazitäten vorhanden sind, wird folgende Reihenfolge der Speisenzubereitung empfohlen:
- Zuerst Speisen zubereiten, die vor dem Verzehr nicht erhitzt werden (z. B. Dessert oder angemachte Salate),
- danach roh zu verzehrende pflanzliche Lebensmittel, wie Salat oder geschnittenes Gemüse,
- zuletzt rohe vom Tier stammende Lebensmittel (z. B. Fleisch, Geflügel).
Sollte diese Reihenfolge aus organisatorischen Gründen nicht eingehalten werden können, ist eine gründliche Zwischenreinigung der Arbeitsflächen und Geräte sowie der Hände zwischen den einzelnen Arbeitsschritten erforderlich.
Kreuzkontaminationen lassen sich durch folgende Maßnahmen vermeiden:
- Beim Umgang mit rohen und gegarten Lebensmitteln nie dieselben Küchenutensilien verwenden
- Für das Schneiden von Fleisch und Geflügel ein Schneidbrett verwenden und ein anderes für Obst und Gemüse
- Gekochte oder anderweitig erhitzte Speisen nicht auf Brettern schneiden, auf denen vorher rohe Lebensmittel geschnitten wurden, wenn diese anschließend nicht ausreichend gereinigt wurden
- Die Hände nach Kontakt mit rohen Lebensmitteln sofort gründlich waschen.
Schneidbretter aus Kunststoff lassen sich in der Regel in Geschirrspülmaschinen bei hohen Temperaturen (deutlich über +60 °C) reinigen und sind deshalb für das Schneiden von rohen Lebensmitteln besser geeignet als Holzbretter. Grundsätzlich sollten Schneidbretter aus Holz oder Kunststoff eine glatte Oberfläche haben, damit sie sich gut reinigen lassen. Schneidbretter mit Einschnitten und Furchen, in denen sich Bakterien halten und vermehren können, sollten deshalb durch neue Bretter ersetzt werden.[82]
Klärwerke
Eine Ozon-Behandlung von Abwässern zerstört insbesondere robuste Bakterienstämme (die tendenziell auch MRSA-Träger sind) nicht.[41]
Textilhygiene
Bei MRSA-besiedelten Personen im Haushalt sollte deren Wäsche nach Möglichkeit im Temperaturbereich > 65 Grad Celsius gewaschen werden.[83]
Meldepflicht
In den Niederlanden sind MRSA-Infektionen seit 2007 meldepflichtig.[84]
In Deutschland ist der Nachweis Methicillin-resistenter Stämme des Staphylococcus aureus namentlich meldepflichtig nach
§ 7 des Infektionsschutzgesetzes, soweit der Nachweis auf eine akute Infektion hinweist und der direkte Nachweis aus Blut oder Liquor
erfolgt. Zudem ist das Auftreten von zwei oder mehr nosokomialen Infektionen
nichtnamentlich zu melden, bei denen
ein epidemischer Zusammenhang wahrscheinlich ist oder vermutet wird.
(
§ 6 Absatz 3 IfSG).
In der Schweiz sind MRSA-Infektionen beim Menschen nicht meldepflichtig.[85]
In Österreich sind MRSA-Infektionen beim Menschen ebenfalls nicht meldepflichtig.[86]
Literatur
- Frank Kipp, Alexander W. Friedrich, Karsten Becker, Christof von Eiff:
Bedrohliche Zunahme Methicillin-resistenter Staphylococcus-aureus-Stämme: Strategien zur Kontrolle und Prävention in Deutschland. In: Deutsches Ärzteblatt 101(28–29), 2004, S. A-2045.
- Marianne Abele-Horn: Antimikrobielle Therapie. Entscheidungshilfen zur Behandlung und Prophylaxe von Infektionskrankheiten. Unter Mitarbeit von Werner Heinz, Hartwig Klinker, Johann Schurz und August Stich, 2., überarbeitete und erweiterte Auflage. Peter Wiehl, Marburg 2009, ISBN 978-3-927219-14-4, S. 226–228.
- Empfehlung zur Prävention und Kontrolle von Methicillin-resistenten Staphylococcus aureus-Stämmen (MRSA) in Krankenhäusern und anderen medizinischen Einrichtungen.
Mitteilung der Kommission für Krankenhaushygiene und Infektionsprävention am RKI. In: Bundesgesundheitsblatt. 42 (12), 1999, S. 954–958.
Informationen zu MRSA ( vom 5. März 2010 im Webarchiv ) PDF downloadbar; RKI; ersetzt durch überarbeitete Version aus dem Jahr 2014; siehe unten
Empfehlungen zur Prävention und Kontrolle von Methicillinresistenten Staphylococcus aureus-Stämmen (MRSA) in medizinischen und pflegerischen Einrichtungen. (PDF; 1,1 MB) Empfehlung der Kommission für Krankenhaushygiene und Infektionsprävention(KRINKO) beim Robert Koch-Institut. In: Bundesgesundheitsblatt. 57 (6), 2014, S. 696–732.
Medizinische Wirksamkeit und Kosten-Effektivität von Präventions- und Kontrollmaßnahmen gegen MRSA-Infektionen im Krankenhaus. (PDF; 47 kB) Kurzfassung des Deutsches Institut für Medizinische Dokumentation und Information-Health Technology Assessment-Berichts vom 17. März 2010, abgerufen am 10. April 2010.
- Robin Köck, Alexander Mellmann, Frieder Schaumburg, Alexander W. Friedrich, Frank Kipp, Karsten Becker: Methicillin-resistenter Staphylococcus aureus in Deutschland:
Epidemiologie. In: Deutsches Ärzteblatt Int. 108(45), 2011, S. 761–767.
(Übersichtsarbeit)
- Robin Köck, Karsten Becker, Markus Bischoff, Christiane Cuny, Tim Eckmanns, Alexandra Fetsch, Dag Harmsen, Stefan Schwarz, Thomas Selhorst, Bernd-Alois Tenhagen, Birgit Walther, Wolfgang Witte, Wilma Ziebuhr: Zur Bedeutung von MRSA als Erreger zoonotischer Erkrankungen in Deutschland. In: Hygiene & Medizin 37 (12), 2012, S. 502–506; für den MedVet-Staph Forschungsverbund.
- Karsten Becker, Cord Sunderkötter: Staphylokokkeninfektion der Haut und Weichgewebe. In: internist. praxis. 55(3), 2015, S. 521–532.
Weblinks
-
Staphylokokken-Erkrankungen, insbesondere Infektionen durch MRSA: RKI-Ratgeber – Informationen des Robert Koch-Instituts
-
MRSA. Robert Koch-Institut, 17. Oktober 2019;
-
Coccus bacteria: one membrane (Gram+): Morphology typical of Staphylococcus aureus – Zelle von Staphylococcus aureus mit Spore, Interaktive Graphik von SwissBioPics, Schweizer Institut für Bioinformatik.
Einzelnachweise
- ↑ Wilhelm Gemoll: Griechisch-Deutsches Schul- und Handwörterbuch. München/Wien 1965.
- ↑ George Y. Liu, Anthony Essex u. a.: Staphylococcus aureus golden pigment impairs neutrophil killing and
promotes virulence through its antioxidant activity. In: Journal of Experimental Medicine. Band 202, 2005.
PMID 16009720,
doi:10.1084/jem.20050846, S. 209–215.
- ↑ Mark A. Holmes, Ruth N. Zadoks: Methicillin Resistant S. aureus in Human
and Bovine Mastitis. In: Journal of Mammary Gland Biology and Neoplasia. Band 16, Nr. 4,
Dezember 2011, S. 373–382,
doi:
10.1007/s10911-011-9237-x.
- ↑ Christof R. Hauck, Franziska Agerer, Petra Muenzner, Tim Schmitter: Cellular
adhesion molecules as targets for bacterial infection. In: European Journal of Cell Biology.
Band 3–4,
Nr. 85, 2006,
S. 235–242,
doi:
10.1016/j.ejcb.2005.08.002.
- ↑ Tamponsicherheit. In: Tampax.ch. Procter & Gamble, 2014,
- ↑ M. Labandeira-Rey, F. Couzon, S. Boisset, E. L. Brown, M. Bes, Y. Benito, E. M. Barbu, V. Vazquez, M. Hook,
J. Etienne: Staphylococcus aureus Panton-Valentine Leukocidin Causes Necrotizing Pneumonia. In:
Science. Band 315,
Nr. 5815, 2007,
S. 1130–1133,
doi:
10.1126/science.1137165.
- ↑ Emma Desgranges, Laura Barrientos, Lucas Herrgott, Stefano Marzi, Alejandro Toledo-Arana:
The 3′UTR-derived sRNA RsaG coordinates redox homeostasis and metabolism adaptation in response to glucose-6-phosphate uptake in Staphylococcus
aureus. In: Molecular Microbiology. Band
117, Nr. 1, Januar 2022,
S. 193–214,
doi:
10.1111/mmi.14845.
- ↑ Samin Kim, Dindo Reyes, Marie Beaume, Patrice Francois, Ambrose Cheung:
Contribution of teg49 Small RNA in the 5′ Upstream Transcriptional Region of sarA to Virulence in Staphylococcus aureus. In:
Infection and Immunity. Band 82,
Nr. 10, Oktober 2014, S. 4369–4379,
doi:
10.1128/IAI.02002-14,
PMID 25092913,
PMC 4187880 (freier Volltext).
- ↑ Clément Chevalier, Sandrine Boisset, Cédric Romilly, Benoit Masquida, Pierre Fechter:
Staphylococcus aureus RNAIII Binds to Two Distant Regions of coa mRNA to Arrest Translation and Promote mRNA Degradation. In:
PLOS Pathogens. Band 6,
Nr. 3, 3. Dezember 2010, S. e1000809,
doi:
10.1371/journal.ppat.1000809,
PMID 20300607,
PMC 2837412 (freier Volltext).
- ↑ Svetlana Chabelskaya, Olivier Gaillot, Brice Feld A Staphylococcus
aureus Small RNA Is Required for Bacterial Virulence and Regulates the Expression of an Immune-Evasion Molecule. In: PLoS Pathogens.
Band 6, Nr. 6, 3. Juni 2010, S.
e1000927,
doi:10.1371/journal.ppat.1000927,
PMID 20532214,
PMC 2880579 (freier Volltext).
- ↑ Hélène Le Pabic, Noëlla Germain-Amiot, Valérie Bordeau, Brice Feld A
bacterial regulatory RNA attenuates virulence, spread and human host cell phagocytosis. In: Nucleic Acids Research.
Band 43,
Nr. 19, 30. Oktober 2015,
S. 9232–9248,
doi:
10.1093/nar/gkv783,
PMID 26240382,
PMC 4627067 (freier Volltext).
- ↑ Tony Mauro, Astrid Rouillon, Brice Feld Insights into the regulation of
small RNA expression: SarA represses the expression of two sRNAs in Staphylococcus aureus. In: Nucleic Acids Research. 4.
September 2016, S. gkw777,
doi :
10.1093/nar/gkw777,
PMID 27596601,
PMC 5137438 (freier Volltext).
- ↑ Chantal Bohn, Candice Rigoulay, Svetlana Chabelskaya, Cynthia M. Sharma, Antonin Marchais:
Experimental discovery of small RNAs in Staphylococcus aureus reveals a riboregulator of central metabolism. In:
Nucleic Acids Research. Band 38,
Nr. 19, Oktober 2010,
S. 6620–6636,
doi:
10.1093/nar/gkq462,
PMID 20511587,
PMC 2965222 (freier Volltext).
- ↑ Nour Sayed, Ambre Jousselin, Brice Feld A cis-antisense RNA acts in
trans in Staphylococcus aureus to control translation of a human cytolytic peptide. In: Nature Structural & Molecular Biology.
Band 19,
Nr. 1, Januar 2012,
S. 105–112,
doi:
10.1038/nsmb.2193.
- ↑ John M. Morrison, Eric W. Miller, Meredith A. Benson, Francis Alonzo, Pauline Yoong:
Characterization of SSR42, a Novel Virulence Factor Regulatory RNA That Contributes to the Pathogenesis of a Staphylococcus aureus USA300
Representative. In: Journal of Bacteriology. Band
194, Nr. 11, Juni 2012,
S. 2924–2938,
doi:
10.1128/JB.06708-11,
PMID 22493015,
PMC 3370614 (freier Volltext).
- ↑ Ting Xue, Xu Zhang, Haipeng Sun, Baolin Sun: ArtR, a novel sRNA of
Staphylococcus aureus, regulates α-toxin expression by targeting the 5′ UTR of sarT mRNA. In:
Medical Microbiology and Immunology. Band
203, Nr. 1, Februar 2014,
S. 1–12,
doi:
10.1007/s00430-013-0307-0.
- ↑ Samin Kim, Dindo Reyes, Marie Beaume, Patrice Francois, Ambrose Cheung:
Contribution of teg49 Small RNA in the 5′ Upstream Transcriptional Region of sarA to Virulence in Staphylococcus aureus. In:
Infection and Immunity. Band 82,
Nr. 10, Oktober 2014,
S. 4369–4379,
doi:
10.1128/IAI.02002-14.
- ↑ Wolfgang Stille: Antibiotika-Therapie: Klinik und Praxis der antiinfektiösen Behandlung. Schattauer Verlag, 2005, ISBN 978-3-79-452160-9, S. 47.
- ↑
Resistenzübersicht. des RKI.
- ↑ Alphabetisches Verzeichnis zur ICD-10-WHO Version 2019, Band 3. Deutsches Institut für Medizinische Dokumentation und Information (DIMDI), Köln, 2019, S. 566
- ↑ M Jevons: Celbenin – resistant Staphylococci. In:
Br Med J. Band 5219,
Nr. 1, Januar 1961,
S. 124–125,
PMC 1952888 (freier Volltext).
- ↑ R. Sutherland, G. N. Rolinson: Characteristics of methicillin-resistant
staphylococci. In: Journal of Bacteriology.
Band 87,
Nr. 4, April 1964,
S. 887–899,
PMID 14137628 (
Zusammenfassung).s
- ↑ Zusammenfassung des Films Tatort Krankenhaus – Warum Händewaschen Menschenleben rettet. und Links zu weiteren Sachinformationen wdr.de
- ↑
Menschen können sich über den Kontakt mit Nutztieren mit Methicillin-resistenten Staphylococcus aureus (MRSA) infizieren. (PDF; 187 kB) BfR, Stellungnahme Nr. 014/2009, 15. März 2009.
- ↑ USA: Fleisch und Geflügel in hohem Maß mit multiresistenten Bakterien kontaminiert. In: Telepolis. 16. April 2011.
- ↑ Andrew E. Waters u. a.: Multidrug-Resistant Staphylococcus aureus in US Meat and Poultry. In:
Clin Infect Dis. 2011,
doi:10.1093/cid/cir181
- ↑ Hochspringen nach: a b
c Wolfgang W. Merkel:
Seifen machen gefährliche Bakterien resistent. In: Die Welt. 2. April 2009.
- ↑ Epidemiologisches Bulletin. Nr. 21, 27. Mai 2013.
- ↑ M. V. S. Import:
Warum Staphylococcus aureus so hartnäckig ist. 14. Juni 2007, abgerufen am 10. März 2024 (deutsch).
- ↑ Melphine M. Harriott, Mairi C. Noverr: Candida albicans and Staphylococcus
aureus Form Polymicrobial Biofilms: Effects on Antimicrobial Resistance. In: Antimicrobial Agents and Chemotherapy.
Band 53,
Nr. 9, September 2009,
S. 3914–3922,
doi:
10.1128/AAC.00657-09,
PMID 19564370,
PMC 2737866 (freier Volltext).
- ↑ Mohammed A. S. Alem, L. Julia Douglas: Effects of Aspirin and Other
Nonsteroidal Anti-Inflammatory Drugs on Biofilms and Planktonic Cells of Candida albicans. In: Antimicrobial Agents and
Chemotherapy. Band 48,
Nr. 1, Januar 2004,
S. 41–47,
doi:
10.1128/AAC.48.1.41-47.2004,
PMID 14693516,
PMC 310207 (freier Volltext).
- ↑ James D. Bryers: Medical Biofilms. In:
Biotechnology and bioengineering. Band
100, Nr. 1, 1. Mai 2008,
S. 1–18,
doi:
10.1002/bit.21838,
PMID 18366134,
PMC 2706312 (freier Volltext).
- ↑ ECDC/EARS-Net: Proportion of Methicillin Resistant Staphylococcus aureus (MRSA) Isolates in Participating Countries in 2012. In: Antimicrobial resistance interactive database (EARS-Net) für das Europäisches Zentrum für die Prävention und die Kontrolle von Krankheiten. European Centre for Disease Prevention and Control (ECDC), 2012.
- ↑
ECDC/EARS-Net: Antimicrobial resistance surveillance in Europe 2012. (PDF) In: Antimicrobial resistance interactive database (EARS-Net) für das Europäisches Zentrum für die Prävention und die Kontrolle von Krankheiten (ECDC). 15. November 2013, S. 6.
- ↑ Matthias Günther: Gefährliche Keime: Immer mehr Infektionen in Schleswig-Holsteins Kliniken. Deutschlandfunk, Sprechstunde, 27. April 2010: „Nach Schätzungen sind in deutschen Krankenhäusern auftretende Keime zu etwa einem Viertel antibiotikaresistent, in den Niederlanden aber nur zu höchstens drei Prozent“.
- ↑ E. E. Udo, J. W. Pearman, W. B. Grubb: Genetic analysis of community isolates of methicillin-resistant
Staphylococcus aureus in Western Australia. In: J Hosp Infect. 25, 1993, S. 97–108.
PMID 7903093.
- ↑ Marianne Abele-Horn (2009), S. 226.
- ↑ M. Bassetti, E. Nicco, M. Mikulska: Why is community-asscociated MRSA spreading across the world and
how will it change clinical practice? In: Int J Antimicrob Agents. 34 Suppl 1, Juli 2009, S. 15–19.
PMID 19560669.
- ↑ M. Hinsch:
emerging drug-resistant microbes challenge today’s healthcare (vom 7. Juni 2014 im Webarchiv)
- ↑ M. W. Wulf u. a.: Prevalence of methicillin-resistant Staphylococcus aureus among veterinarians: an
international study. In: Clinical Microbiology and Infection. 6. November 2007,
doi:10.1111/j.1469-0691.2007.01873.x
- ↑ Hochspringen nach: a b
c d e
f vfmy:
Die Brutstätte für die Super-Erreger. auf: Badische-zeitung.de – Bildung & Wissen, 4. Juni 2016.
- ↑
rense.com: MRSA Superbug Now Found On US Beaches (19. Juni 2016)
- ↑ Carsten Upadek:
Superbakterien vor Rios Stränden. In: deutschlandfunk.de – Sport am Wochenende. 19. Juni 2016.
- ↑ T. Khanna u. a.: Methicillin resistant Staphylococcus aureus colonization in pigs and pig farmers. In: Vet. Microbiol. Press, Accepted Manuscript, Available online 16. Oktober 2007. doi:10.1016/j.vetmic.2007.10.006
- ↑ Michael Pollan:
The Way We Live Now – Our Decrepit Food Factories. In: The New York Times. 23. Februar 2007.
- ↑ Hochspringen nach: a b
Gudrun Heyn:
Problemkeime in der Nahrung. In: Pharmazeutische Zeitung. 19/2009.
- ↑ R. Woltering u. a.: MRSA-Prävalenz in medizinischen und pflegerischen Einrichtungen eines Landkreises /
Prevalence of methicillin-resistant Staphylococcus aureus (MRSA) in patients in long-term care in hospitals, rehabilitation centers and nursing homes of a rural district in
Germany. In: Deutsche Medizinische Wochenschrift 133(19), 2008, S. 999–1003.
PMID 18446675,
doi:10.1055/s-2008-1075683
- ↑ Gefährliche Keime – Immer mehr Infektionen in Schleswig-Holsteins Kliniken. Deutschlandfunk, 27. April 2010.
- ↑ R. M. Klevens u. a.: Invasive Methicillin-Resistant Staphylococcus aureus Infections in the United
States. In: Journal of the American Medical Association. 298(15), 17. Oktober 2007, S. 1763–1771.
doi:10.1001/jama.298.15.1763
- ↑
Krank durch die Klinik. In: Focus online. 26. Februar 2010.
- ↑ Hochspringen nach: a b Killerbrut, die verschwiegene Katastrophe. Westdeutscher Rundfunk, Fernsehen, „die story“, Sendung vom 26. Oktober 2009.
- ↑
Deutsche Gesellschaft für Krankenhaushygiene e.V.
- ↑ Killerkeime in Klinik „Schicksal ist, wenn man im falschen Krankenhaus landet“. In: Westdeutsche Allgemeine Zeitung. 27. Februar 2014.
- ↑
Linezolid (Zyvoxid): Erhöhte Mortalität bei schweren Haut- und Weichteilinfektionen, die nicht ausschließlich durch grampositive Erreger verursacht werden – Anwendungsbeschränkungen beschlossen. (vom 1. Mai 2010 im Webarchiv) Bundesinstitut für Arzneimittel und Medizinprodukte, Pharmakovigilanz/Risikoinformationen, 16. März 2007.
- ↑ Marianne Abele-Horn: Antimikrobielle Therapie. Entscheidungshilfen zur Behandlung und Prophylaxe von Infektionskrankheiten. Unter Mitarbeit von Werner Heinz, Hartwig Klinker, Johann Schurz und August Stich, 2., überarbeitete und erweiterte Auflage. Peter Wiehl, Marburg 2009, ISBN 978-3-927219-14-4, S. 194 und 226–228.
- ↑
Landesarbeitsgemeinschaft resistente Erreger (LARE): Empfehlungen zur Sanierung von Patienten mit MRSA-Nachweis (Stand: 25.09.2019). (PDF; 336 kB) Abgerufen am 10. Dezember 2019.
- ↑ Marianne Abele-Horn (2009), S. 228.
- ↑ Neues Antibiotikum treibt Bakterien in den Selbstmord. Uni Bonn, 5. Oktober 2011:
- ↑ A Cholesterol Lowering Agent Inhibits «Staphylococcus aureus» Virulence. In: Science.
319(5868), 7. März 2008, S. 1391–1394.
doi:10.1126/science.1153018,
PMC 2747771 (freier Volltext)
- ↑ Tadayuki Iwase u. a.:
Staphylococcus epidermidis Esp inhibits Staphylococcus aureus biofilm formation and nasal colonization. In: Nature. Band 465, Nr. 7.296, S. 346. Jikei University School of Medicine, Tokyo
- ↑ F. Aqil u. a.: Effect of certain bioactive plant extracts on clinical isolates of beta-lactamase
producing methicillin resistant Staphylococcus aureus. In: J Basic Microbiol. 45/2/2005, S. 106–114.
PMID 15812867
- ↑ S. Singh u. a.: Antibacterial activity of Ocimum sanctum L. fixed oil. In: Indian J Exp Biol.
43(9), Sep 2005, S. 835–837.
PMID 16187537
- ↑ Klaus Hönninger: Impacto de la combinacion de Croton Lechleri, Piper Angostifolium y Plantago Major en la curacion de Estafiloco Aureus en las vias respiratorias superiores. Ethnoline Peru, Lima 2006.
- ↑ Himalayan Oregano Effective Against MRSA. In: Medical News Today. 24. November 2008,
- ↑ Scientists win SEED award for Himalayan oregano project. University of the West of England, 28. Oktober 2008.
- ↑ A. M. Kropinski: Phage therapy – everything old is new again. In: Can J Infect Dis Med
Microbiol. (17), 2006, S. 297–306.
PMID 18382643
- ↑ R. Miedzybrodzki u. a.: Phage therapy of staphylococcal infections (including MRSA) may be less
expensive than antibiotic treatment. In: Postepy Hig Med Dosw. (61), 2007, S. 461–465.
PMID 17679835
- ↑ B. L. Herpers: Specific lysis of methicillin susceptible and resistant Staphylococcus aureus by the endolysin Staphefekt SA.100™. European Congress of Clinical Microbiology and Infectious Diseases, 10. Mai 2014.
- ↑
Neues Antibiotikum in der Nase entdeckt. orf.at, 27. Juli 2016, abgerufen am 28. Juli 2016.
- ↑ Hochspringen nach: a b Katja Schmidt:
Chefs müssen gute Hygiene vorleben. In: Ärzte Zeitung. 26. Juni 2009. Abgerufen am 10. November 2009.
- ↑ Prevention and control of methicillin-resistant Staphylococcus aureus.
PMID 19291143.
- ↑
Vorstellung der LandesArbeitsgemeinschaft MultiResistente Erreger (LARE) LGL Bayern
- ↑
Problemkeime im Krankenhaus. auf: badische-zeitung.de, 6. September 2010.
- ↑ Umgang mit MRSA UKM – Institut für Hygiene
- ↑ Infektionen mit Methicillin-resistentem Staphylococcus aureus: Bedeutung des Pathogenitätsfaktors Panton-Valentine Leukozidin. In: Deutsche Medizinische Wochenschrift. 130(11), 18. März 2005, S. 582–585; quiz 589–592.
- ↑
Verordnung soll tödliche Infektionen in Kliniken eindämmen. In: Badische Zeitung. 21. April 2010.
- ↑
Keime in Klinik Land setzt auf neue Hygieneverordnung. In: Badische Zeitung. 4. August 2010.
- ↑ MedHygVO vom 20. Juli 2012, GBl. S. 510 (
Digitalisat (PDF; 103 kB) ).
- ↑ HygMedVO vom 13. März 2012, GV NRW, S. 143. (
online).
- ↑ Bayerische Medizinhygieneverordnung – MedHygV vom 1. Dezember 2010, GVBl. S. 817 (
online).
- ↑
MRSA im Krankenhaus: Prävention und Kontrolle erfolgreich – Weitere Forschung notwendig. (vom 2. August 2012 im Webarchiv) DIMDI-Pressemitteilung vom 17. März 2010, abgerufen am 10. April 2010.
- ↑
Schutz vor Lebensmittelinfektionen im Privathaushalt. (PDF; 433 kB) Infoblatt des Bundesinstitutes für Risikobewertung
- ↑ Informationen zu MRSA für Patienten und Angehörige. (PDF; 246 kB) TLLV Bad Langensalza, Abteilung Medizinaluntersuchung, Stand: Januar 2012.
- ↑
- ↑
Faktenblatt zu MRSA. (PDF) Eidgenössisches Departement des Innern EDI : Bundesamt für Lebensmittelsicherheit und Veterinärwesen BLV,: „Infektionen mit MRSA beim Menschen sind in der Schweiz nicht meldepflichtig.“ (Autom. Download)
- ↑ Methicillin-resistenter Staphylococcus aureus (MRSA). (PDF) Medizinische Universität Wien/Universitätsklinikum AKH Wien, 4 Juli 2022.
- ↑ National Center for Biotechnology Information Taxonomy Browser:
Staphylococcus phage SA3 (species)



© biancahoegel.de
Datum der letzten Änderung: Jena, den: 06.04. 2025